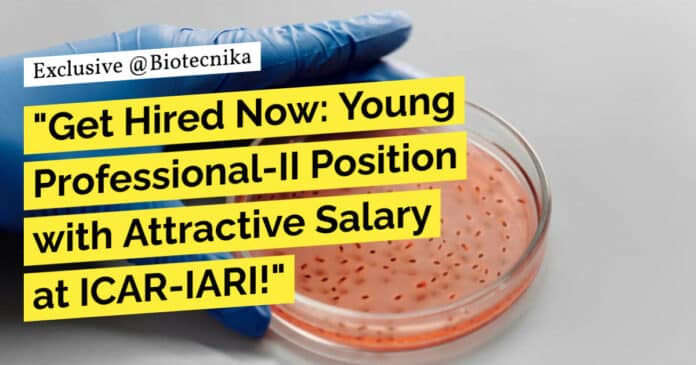

ICAR-IARI Molecular Biology Young Professional Job – Apply Now
Division of Microbiology
ICAR INDIAN AGRICULTURAL RESEARCH INSTITUTE
NEW DELHI-110012
Walk-in interview
Applications are invited for the post of Young Professional-II (one post) in SPUN Underground Explorers Program entitled “Abundance and Diversity of AMF in the North-Eastern Hill of India”, purely on contractual basis (as indicated below). The walk-in interview is scheduled to be held on 29.01.2024 at ICAR-Indian Agricultural Research Institute, Pusa, New Delhi 110012 at 11.00 AM.
| Sr. No. | Name of the Post | No. of Post | Emoluments (Fixed) Per Month | Essential Qualifications | Desirable Qualifications |
| 1 | Young Professional-II | One | Rs. 35,000/- | Postgraduate in Microbiology/Agricultural Microbiology/Molecular Biology and Biotechnology/Plant Pathology/Ag. Botany | Experience in Molecular Identification (Sequencing of ITS/16S rDNA region (partial) and BLAST Analysis) and basic computer knowledge |
Terms & Conditions:
- Age limit: The minimum age for Young Professional-II will be 21 years and maximum 45years. Age relaxation as per rules.
- The posts are purely temporary and will be filled on a contractual basis for 6 months from joining date whicht maybe extended further based on the performance of the candidate or till the termination of the project whichever is deemed fit.
- The candidate shall not claim regular appointment at this Institute, as the positions co-terminus with the project.
- The candidates will have to compulsorily fill in application form (as per the format annexed), all the copy certificates from matriculation onwards, date of birth certificate, NET/equivalent certificate, degree certificateeither original or provisional and a recent photograph enclosed onto the application form. Proof of experience and publications must also be attached with the application form.
- The selected candidate will be required to produce all the original documents at the time of joining.
- No TA/DA/any other expenses will be paid for attending the interview.
- Only the candidates having essential qualifications would be entertained for the interview.
- Concealing of facts or canvassing in any form shall lead to disqualification or termination.
- The candidate intending to attend the interview, if any of his/her near or distant relative is an employee of the ICAR/IARI, have to declare his/her name, designation, nature of duties, relationship in writing before the interview date.
- All the other candidates are also required compulsorily to submit the scan declaration duly signed in the format annexed along with other documents in the e-mail.
Download the application format here
Keywords: ICAR-IARI, Young Professional-II, Microbiology, Molecular Biology, Biotechnology, Walk-in Interview, Temporary, Contractual. ICAR-IARI Molecular Biology Young Professional Job – Apply Now. Please ensure you are subscribed to the Biotecnika Times Newsletter and our YouTube channel to be notified of the latest industry news. Follow us on social media like Twitter, Telegram, Facebook

Plz tell me ,about procedure to fill the form